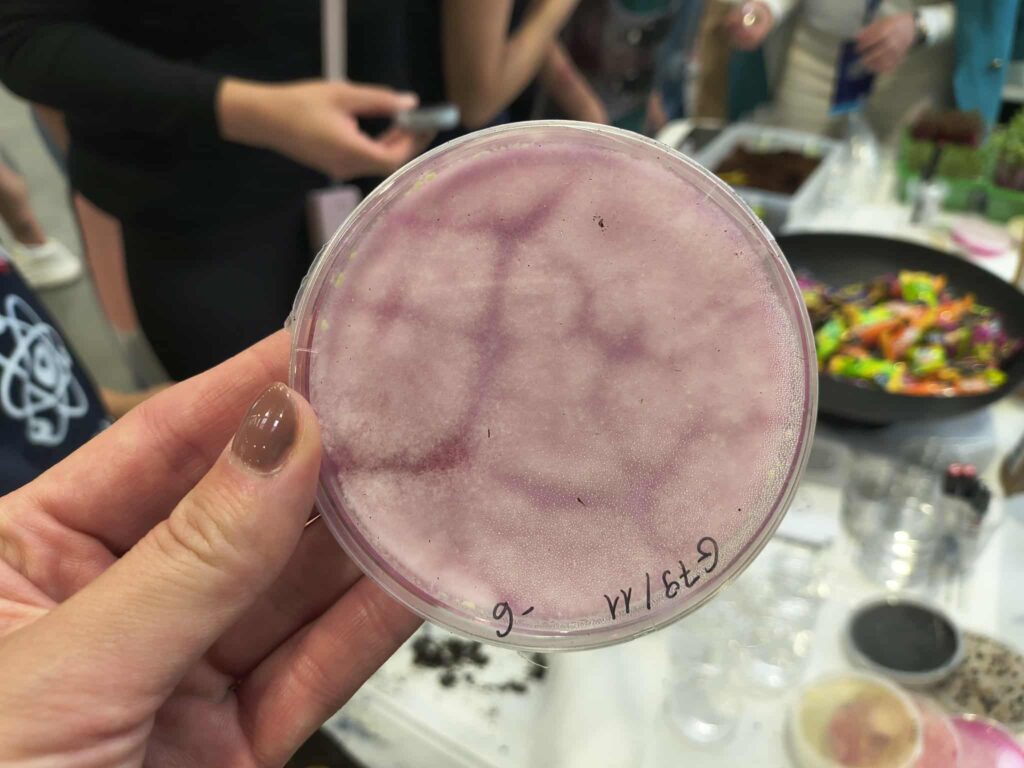

Pokaz “Kampanii Bioróżnorodność” w ramach Lubelskiego Pikniku Naukowego

Lubelski Festiwal Nauki rozpoczęty!
Dziś na Targach Lublin wystartowała tygodniowa, naukowa przygoda całego miasta – Lubelski Festiwal Nauki 🙃
Tegoroczna edycja odbywa się pod hasłem „Inżynieria życia”, które znakomicie oddaje nowoczesne, interdyscyplinarne podejście do nauki, technologii i zrównoważonego rozwoju 🙂
Z ogromną radością nasza kampania również dołączyła do programu wydarzenia 😊
Przygotowaliśmy dla Państwa pokaz „Holobiont roślinny, mikrobiom glebowy, microgreens – co to takiego?”, w którym przybliżyliśmy znaczenie interakcji gleba–roślina–mikrobiom w zrównoważonej produkcji rolniczej. Opowiedzieliśmy m.in. o badaniach nad holobiontem roślinnym oraz mikrobiomami glebowymi
Ogromne brawa należą się także naszym wolontariuszom, którzy z pasją prowadzili kampanię informacyjną dotyczącą projektu – niezmiernie ważny element informowania społeczności o konieczności zachowania bioróżnorodności!
Bądźcie z nami na bieżąco, aby nie przegapić kolejnych pokazów i atrakcji festiwalowych!
Projekt realizowany w ramach Programu Fundusze Europejskie dla Polski Wschodniej 2021–2027
Wartość projektu: 2 791 092.36 PLN
Wkład z Funduszy Europejskich: 2 270 428.50 PLN
#FunduszeUE #FunduszeEuropejskie
